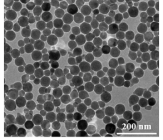

├¹ĘQŻ║PC/UCNPs░l╣Ō╝{├ū╠Įßś
ĮM│╔Ż║PEI-NaGdF4:Yb,ErĪóPC
┴ŻÅĮŻ║50nm
æ¬ė├Ż║čū░Y▀^│╠ųą│╔Ž±
ā”┤µŚl╝■Ż║-4Īµ
Ųõ╦¹šf├„Ż║├▄ĘŌĀŅæBŽ┬▒Ż┘|Ų┌░ļ─ĻĪŠų„ę¬ā×ä▌Ī┐1ĪóīŹ“×═©▀^§Ż░Ę╗»Ę┤æ¬īóPCĮėų”ĄĮUCNPs▒Ē├µŻ¼PC┐╔═©▀^─▄┴┐é„▀füĒęųųŲUCNPsĄ─░l╣ŌĪŻ═¼ĢrŻ¼įō╠Įßśę▓┐╔ė├ė┌ī”MPOĄ─╔·╬’╗Ņąį▀MąąįuārŻ╗2ĪóīŹ“×ę▓ęį╝▒ąįĖ╬ōpé¹ąĪ╩¾×ķ─Żą═Ż¼ūC├„┴╦╗∙ė┌PC-UCNPsĄ─╝{├ū╠Įßś┐╔ęį│╔╣”Ąž▒╗æ¬ė├ė┌ī”╗Ņ╝Ü░¹║═čū░Y▀^│╠ųąĄ─MPO▀Mąą╔·╬’│╔Ž±ĪŻ
Ņ}─┐Ż║
Rational Modulation of the Luminescence of Upconversion Nanomaterials with Phycocyanin for the Sensing and Imaging of Myeloperoxidase during an Inflammatory Process
╬─š┬µ£ĮėŻ║
https://mp.weixin.qq.com/s?src=11Ī┴tamp=1688544166&ver=4631&signature=eazMyMSpK0qZz2LZjVFYRLgTzwk3VijfNVpZybCS1t2hqLEB11QmFUxQnQCSF54wt57OdbDG36SCcKE7*ULY9efVZcrySKpBNxKUBEkdoklsqc0fT3hLkNQvJlXYH8AD&new=1

┴¶čįū╔įā
┴¶čįū╔įā
|
|
 |
| ╔·╬’╝{├ū▓─┴ŽŪ░čž |
 |
| ╝{├ūßtīWFrontier |
|
£ž▄░╠ß╩ŠŻ║╠Kų▌▒▒┐Ų╝{├ū╣®æ¬«aŲĘāHė├ė┌┐Ų蹯¼▓╗─▄ė├ė┌╚╦¾w,▓╗═¼┼·┤╬«aŲĘęÄĖ±ąį─▄ėą▓Ņ«ÉĪŻŠWšŠ▓┐Ęų╬─½I░Ė└²łDŲ¼į┤ūį╗ź┬ōŠWŻ¼łDŲ¼āH╣®ģó┐╝Ż¼šłęįīŹ╬’×ķų„Ż¼╚ńėąŪųÖÓšł┬ōŽĄ╬ęéā┴ó╝┤äh│²ĪŻ
╠ß╩Ššf├„Ż║╝{├ū▓─┴Ž╣ż╦ć║═ųŲéõ┐╔─▄Ģ■ėąĖ─ūā ╦∙ėą╝{├ū▓─┴ŽŠ∙ų¦│ų░┤ąĶČ©ųŲ Ž┬å╬Ū░┬ōŽĄ┐═Ę■┤_šJ«aŲĘįö╝Üą┼ŽóĪŻ |
